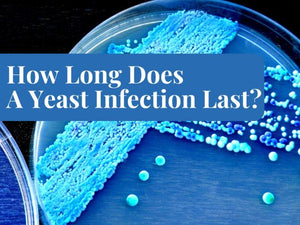
How Long Does A Yeast Infection Last? Treat Before You Repent

It is to be noted that a yeast infection not always means a vaginal infection. Yeast belongs to the kingdom of fungi and has over 1500 different species. Amongst the pathogenic yeasts, Candida albicans and Cryptococcus neoformans commonly cause diseases and infections in human beings. Being the most virulent, Candida causes several maladies like vulvovaginitis, cystitis, and dermatitis. More importantly, Candida not only thrives and proliferates in the vagina but can also infect skin, nails, mouth, navel, and penis.

Also, several other infections have symptoms similar to vaginal or penile yeast infections. As a result, people can’t diagnose an infection right for the proper treatment. Therefore, if you want to answer the query How can I tell if I have a yeast infection in the vagina or penis, follow along.
Symptoms Of Yeast Infection In Particular Body Parts
Yeast can proliferate in various body areas and cause infection. Here are the symptoms of yeast infection in particular body parts.
In Mouth (Oral Thrush):
- White patches or creamy white lesions on the tongue and inside cheeks
- Feeling cotton on the tongue
- Redness, swelling, burning, and soreness in the mouth
- Loss of taste and difficulty swallowing food
- Bleeding from cracks
In Vagina (Vaginal Thrush):
- Thick white vaginal discharge resembling cottage cheese
- Burning and irritation
- Redness and swelling
- Offensive odor
- Itchiness and rash
In Penis (Penile Thrush):
- Thick white discharge accumulating in skin folds
- Shiny white patches throughout the length of the penis
- Itchiness, burning, and irritation
- Swelling and rash
In Navel:
- Redness and cracks
- Pimples oozing clear fluid
- Burning and itchiness
In Nails:
- Yellowish nail bed
- Nail separating from the nail bed
- Swelling and pus accumulation
- Pain
Infections Similar To Vaginal Yeast Infection- Point Out The Difference
How can I tell if I have a yeast infection or not? Several infections and diseases have symptoms similar to vaginal yeast infections. Therefore, you should differentiate among them for accurate diagnosis and proper treatment.
Bacterial Vaginosis
| Bacterial Vaginosis | Vaginal Yeast Infection |
| Overgrowth of bacteria (Gardnerella vaginitis) | Overgrowth of yeast(Candida albicans) |
| Yellowish, whitish grey discharge | Creamy white or white discharge |
| Discharge with fishy odor | Discharge may or may not be smelly |
| Relatively thin discharge | Thick cottage cheese like discharge |
| May not be red or inflamed genitalia | Noticeably red and inflamed genitalia |
| Burning sensation while urinating | Burning sensation while urinating and having intercourse |
| Treated with prescription antibiotics | Treated with OTC or prescription antifungals |
Vaginal Atrophy/Dryness
| Vaginal Atrophy/Dryness | Vaginal Yeast infection |
| Vaginal dryness | Rarely cracks and sores when worsen |
| Bleeding or spotting | No bleeding |
| Feeling pressure and urge to urinate | No pressure feeling |
Other symptoms like itchiness, redness, swelling, pain during urination and sex are common in both conditions. Differentiate accurately or consult a physician for proper diagnosis.
Also Read: How Long To Wait For Sex After Yeast Infection Treatment
STD And UTIs
How to know if I have a yeast infection or a UTI? Sexually transmitted diseases like trichomoniasis, genital warts, chlamydia, gonorrhea, pubic lice, genital herpes, and UTIs have similar symptoms to that yeast infections, for example, itchiness, irritation, and pain in the genitalia with vaginal discharge and slight lousy odor. Since different microbes cause these infections, accurate diagnosis is necessary for the problem of how to know if I have a vaginal yeast infection. Moreover, it is crucial for proper treatment.
Allergic Reactions
Allergic reactions, when exposed to scented and chemical-laden cosmetic products, can also cause itching, irritation, burning, redness, and swelling in the vagina. Consequently, the vagina may produce excessive discharge. Identify the causes of vaginal yeast infection and remember if you have used an irritant before the symptoms appear. It is because allergic reactions require treatment with oral or topical antihistamines and corticosteroid therapy, whereas vaginal yeast infections need antifungals for correction.
Skin Diseases
Several skin diseases, like eczema and psoriasis, can cause vaginal dryness, cracking, soreness, and itchiness. However, these conditions do not produce excessive vaginal discharge in thick consistency like cottage cheese and do not cause pain during intercourse. Seek medical assistance to answer how to know if I don’t have a yeast infection.
Hemorrhoids
Hemorrhoids can be itchy due to dryness or infection surrounding the vaginal area. Experiencing itchiness, however, does not mean you get a vaginal yeast infection. Double-check the symptoms of the vaginal yeast infection enlisted above and consult a doctor for an accurate diagnosis.
Hormonal Imbalance
Hormonal imbalances like low estrogen levels can alter the normal physiology of your vagina, which can result in itchiness and dryness. An itchy vagina does not always mean a vaginal yeast infection since the latter is characterized by cheesy white discharge and inflammation.
How Can I Tell If I Have A Yeast Infection? Diagnosis
If you want to answer the query of how to know if I have a yeast infection, make an accurate diagnosis yourself or with the help of a physician.
Taking Medical And Medication History
Know if you have any past infections or allergic reactions to irritants you have recently used. Determine if you/the patient is taking any medication like antibiotics that can make you prone to yeast infection.
Physical Examination Of Genitalia
Physically examine the genitalia and pelvic region for signs of inflammation, and itchiness, cracking. Observe vaginal discharge color and odor. Moreover, a doctor can use a speculum to see inside the vagina and cervix.
Testing Vaginal Discharge
Take a sample of vaginal secretions and conduct a laboratory test to see if the microbes present in the discharge is the yeast or bacteria.
Know The Causes To Make Differential Diagnosis
How to know if I have a UTI or yeast infection? Know the causes to make a differential diagnosis.
- You may be using too many antibiotics
- Weakened immune system
- Unhygienic practices
- Taking oral contraceptives
- Wearing tight and damp undergarments
- Using scented products
- Doing excessive douching
- Hormonal imbalance
Treatment Of Yeast Infection:
After knowing the answer of how to know if I have a yeast infection, you can begin treating it.

Vaginal Yeast Infection
- Short-term vaginal yeast infection treatment with miconazole (Monistat 3) and terconazole for about 3-7 days or a single dose of fluconazole for one day
- Long-term yeast infection treatment with antifungals for about two weeks
- Multidose medication therapy with two to three doses of antifungals daily
- Boric acid capsules for insertion into the vagina for azole-resistant patients
Other Yeast Infections
- Oral thrush should be treated with lozenges or mouthwash
- Esophageal yeast infection should be treated with oral IV antifungals
- Yeast infection of nails should be treated with oral antifungals
- Skin yeast infection are treated with TDS/ patches or topical powders
In Conclusion
It is crucial to answering how to know if I have a UTI or yeast infection because an accurate diagnosis is a prerequisite for rational therapy. Suppose you are sure that the itchiness and inflammation is a yeast infection or not bacterial vaginosis or other infection. In that case, you can treat and manage it properly, or it will worsen, making diagnosis difficult.
 Proudly Made in the USA
Proudly Made in the USA